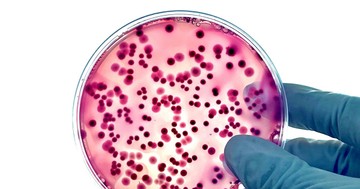
Antibiotikumokkal és vírusokkal a szuperbaktériumok ellen

Mivel a törölközőt naponta többször és nedves környezetben használjuk, könnyen elszaporodhatnak rajta a baktériumok és a gombák. A szakértők szerint ezért nem mindegy, milyen gyakran kerül a mosógépbe.
A törölköző a mindennapi higiénia része, mégis sokan hajlamosak megfeledkezni arról, hogy rendszeresen ki kellene mosni.
Mi történik a törölközőn használat után?
Amikor törölközővel szárítjuk meg magunkat, nemcsak a vizet töröljük le a bőrről. A bőrön természetesen jelen lévő baktériumok, az elhalt hámsejtek és az izzadság maradványai is rákerülnek az anyagra.
Ha a törölköző használat után nedves marad, a mikroorganizmusok könnyebben elszaporodhatnak rajta, különösen meleg és párás környezetben.
Általában 3–4 használat után érdemes kimosni
A szakértők többsége azt javasolja, hogy a fürdőlepedőt körülbelül három-négy használat után mossuk ki. Ez nagyjából heti két mosást jelent, ha naponta zuhanyzunk.
Természetesen ez attól is függ, mennyire szellős helyen szárad a törölköző. Ha gyorsan megszárad két használat között, kevésbé szaporodnak rajta a baktériumok.
Gyakrabban kell mosni bizonyos esetekben
Vannak helyzetek, amikor érdemes sűrűbben mosni a törölközőket. Például akkor, ha valaki beteg, bőrfertőzése van, vagy intenzív edzés után használja őket.
Ilyenkor a higiénia szempontjából jobb, ha már egy-két használat után a mosógépbe kerülnek.
Fontos a megfelelő szárítás is
Nemcsak a mosás gyakorisága számít, hanem az is, hogyan szárítjuk a törölközőt. Ha használat után összehajtva hagyjuk vagy nedves helyen marad, könnyebben kellemetlen szaga lehet.
A szakértők szerint érdemes úgy kiteríteni, hogy minél gyorsabban megszáradjon.
Mikor kell új törölközőt venni?
A törölközők idővel elhasználódnak: a szálak keményebbé válhatnak, és a nedvszívó képességük is romlik. Ha már nehezen szárít, vagy állandóan kellemetlen szaga van még mosás után is, ideje lecserélni.
A megfelelően tisztított és szárított törölköző nemcsak higiénikusabb, hanem tovább is használható.
Összegzés
- A törölközőket 3-4 használat után ajánlott kimosni a szakértők szerint.
- Nedves környezetben gyorsan elszaporodhatnak rajtuk a baktériumok és gombák.
- Bizonyos esetekben, például betegség vagy intenzív sportolás után, sűrűbben kell mosni.
- Fontos, hogy a törölköző gyorsan és teljesen megszáradjon használat után.
- Ha a törölköző elveszíti nedvszívó képességét vagy kellemetlen szaga marad, ideje lecserélni.
Antibiotikumokkal és vírusokkal a szuperbaktériumok ellen
Kövesse az Egészségkalauz cikkeit a Google Hírek-ben, a Facebook-on, az Instagramon vagy a X-en,Tiktok-on is!









